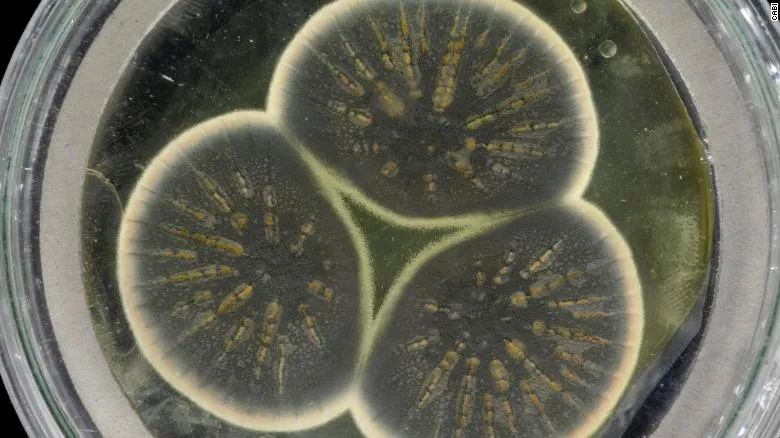
研究超级细菌,科学家研究超级细菌

预计到2050年,细菌的耐药性将造成每年1000万人死亡。细菌耐药问题亟需解决。
最近,来自帝国理工学院、牛津大学以及国际应用生物科学中心(CABI)的学术团队对弗莱明发现的初代青霉菌菌株进行了基因组测序。研究人员认为,通过比对生代分泌青霉菌菌株和当下工业生产使用的菌株在分泌青霉素方面的遗传差异,有望指引科学家摸索出设计新型抗生素的方法,进而帮助人类攻克细菌耐药性难题。研究成于近日发表在《科学报告》(Scientific Reports)杂志上。
1928年,弗莱明在伦敦圣玛丽医院医学院工作时发现了青霉素,该医学院后被并入帝国理工学院
1928年,亚历山大·弗莱明(Alexander Fleming)意外发现青霉素。当时,他正用显微镜观察被霉菌污染的培养皿,结果发现霉菌周围的葡萄球菌菌落溶解了——这意味着霉菌的某种分泌物能抑制葡萄球菌。
之后,他确认这些具备抑菌能力的霉菌为青霉菌,并将其分泌物命名为青霉素。这一事件直接改变了现代医学的发展方向,以青霉素为代表的抗生素自此登上历史舞台,成为20世纪人类治疗众多疾病的法宝。弗莱明也因此获得1945年的诺贝尔生理学或医学奖。
弗莱明付出了极大心血确定其显微镜下的初代青霉菌究竟属于何种菌株。经过多年努力,他确定了几种具备分泌青霉素能力的青霉菌菌株。而在20世纪30年代至40年代,英国和美国的科学家评估了许多不同的菌株,希望能找出可用于批量生产的好苗子。他们的努力很快换来了无比可贵的回报,二战期间有数千名受伤的士兵和平民因充足的青霉素供应获救。
不过隐患也随普及一同出现。
弗莱明很早就意识到细菌耐药性的威胁。他在1945年被授予诺贝尔奖时的演说中表达了对此的担忧:“也许到任何人都能在药店购得青霉素的时候,危险就会来临,有些人的用药量不足以剿灭目标微生物,那些细菌被暴露于非致命剂量的*伤杀**下,在长期的定向选择中演化出抗性。”
冷冻几十年,苏醒片刻间
如今,科学家又将目光转回弗莱明的初代青霉菌。本文开头提到科学家首次对其基因组进行了测序,在他们看来,基因组的信息很可能会成为通向抗生素自由的钥匙。
帝国理工学院和牛津大学的教授蒂姆·巴拉克拉洛(Tim Barraclough)是此项新研究的重要参与者,他表示:
“青霉菌在冷冻保存很长一段时间后,仍可以很快恢复生长状态。操作也一点不复杂,你要做的只是把它从试管中取出,放到培养皿上,然后等待它回归常态。不过有一点令我非常惊讶——在我们之前,竟然没有人给初代青霉菌做基因组测序,要知道其历史意义可以说是划时代的。”


木盒里保存着弗莱明的初代青霉菌样品
帝国理工和牛津的合作机构——CABI是一个非营利性政府间组织,成立于1929年,主要致力于解决发展中世界的农业和环境问题,以及创造、整合并传播科学知识,现有47个成员国。
CABI下属的生物科学部保存有初代青霉菌的冷冻样本,合计30000株菌株,它们从1945年开始就一直处于冷冻状态。他们向巴拉克拉洛的研究团队提供了这些曾为弗莱明带来惊喜的珍贵培养物。
实际上,这并非抗生素元老们的首次解冻。2019年,CABI的工作团队就曾从菌种保存库内取出这些初代青霉菌,令其恢复正常生长状态,然后带着从原始菌株中生长出来的它们前往中国和印度展出。
超级细菌终结者?
“人们一直在努力寻找全新的抗生素,但核心问题在于:5~10年,细菌就适应了每种新抗生素。”
巴拉克拉洛等人将弗莱明的初代青霉菌与另外两种来自美国的青霉菌株(用于工业级抗生素生产)进行了遗传信息的比较。
他们着眼于两类基因:一类编码青霉素分泌所需的酶;另一类负责调控这些酶(例如调控酶的分泌量)。

这支管子改变了医学史
巴拉克拉洛希望找到这两类关键基因在青霉菌自然演化中产生的差异(虽然非常微小),因为这将有助于我们摸清微生物生产抗生素的过程——如果能完全理解生产机制,就可以自行修改生产过程,进而有能力持续地设计新型抗生素,突破超级细菌耐药性这个当代医学领域内的卡脖子问题。

END
资料来源:
Scientists sequence the 92-year-old mold that produced the first antibiotic, penicillin
一键三连关注